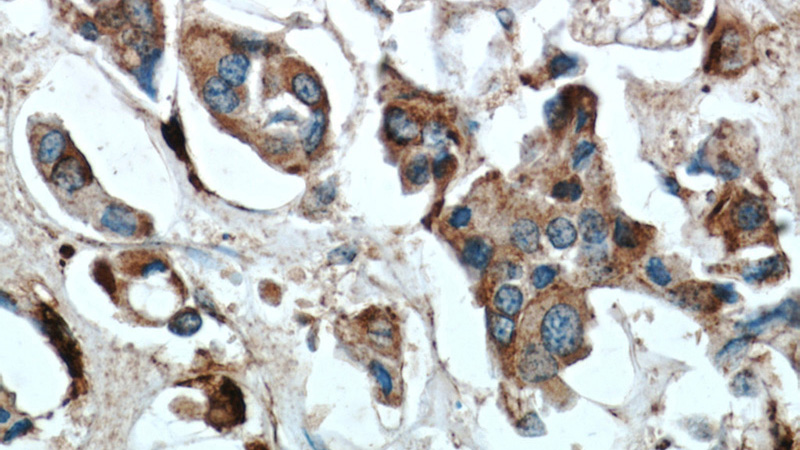
Immunohistochemical of paraffin-embedded human breast cancer using Catalog No:108888(CTSD antibody) at dilution of 1:50 (under 40x lens)

-
Product Name
Cathepsin D antibody
- Documents
-
Description
Cathepsin D Rabbit Polyclonal antibody. Positive WB detected in MCF7 cells, A431 cells, HepG2 cells, HT-1080 cells, L02 cells. Positive IF detected in HepG2 cells. Positive IHC detected in human breast cancer tissue, human hepat℃irrhosis tissue, human liver cancer tissue. Observed molecular weight by Western-blot: 48-52 kDa
-
Tested applications
ELISA, WB, IF, IHC
-
Species reactivity
Human, Mouse, Rat; other species not tested.
-
Alternative names
cathepsin D antibody; CLN10 antibody; CPSD antibody; CTSD antibody
-
Isotype
Rabbit IgG
-
Preparation
This antibody was obtained by immunization of Cathepsin D recombinant protein (Accession Number: NM_001909). Purification method: Antigen affinity purified.
-
Clonality
Polyclonal
-
Formulation
PBS with 0.02% sodium azide and 50% glycerol pH 7.3.
-
Storage instructions
Store at -20℃. DO NOT ALIQUOT
-
Applications
Recommended Dilution:
WB: 1:500-1:5000
IHC: 1:20-1:200
IF: 1:10-1:100
-
Validations

MCF7 cells were subjected to SDS PAGE followed by western blot with Catalog No:108888(CTSD antibody) at dilution of 1:1000

Immunohistochemical of paraffin-embedded human breast cancer using Catalog No:108888(CTSD antibody) at dilution of 1:50 (under 10x lens)
Immunohistochemical of paraffin-embedded human breast cancer using Catalog No:108888(CTSD antibody) at dilution of 1:50 (under 40x lens)

Immunofluorescent analysis of HepG2 cells, using CTSD antibody Catalog No:108888 at 1:25 dilution and Rhodamine-labeled goat anti-rabbit IgG (red).
-
Background
CTSD(Cathepsin D) is also named as CPSD,belongs to the peptidase A1 family.It is ubiquitously expressed and is involved in proteolytic degradation, cell invasion, and apoptosis. The prepro-CTSD isoform has a molecular mass of 52 kDa, the pro-CTSD 48 kDa and the mature CTSD 32 kDa(PMID:10917609). It is a lysosomal acid protease found in neutrophils and monocytes and involved in the pathogenesis of several diseases such as breast cancer and possibly Alzheimer disease.Defects in CTSD are the cause of neuronal ceroid lipofuscinosis type 10 (CLN10).This antibody is specific to CTSD.
-
References
- Liu Z, Chen C, Yang H. Proteomic features of potential tumor suppressor NESG1 in nasopharyngeal carcinoma. Proteomics. 12(22):3416-25. 2012.
- Shu G, Mi X, Cai J. Brucine, an alkaloid from seeds of Strychnos nux-vomica Linn., represses hepatocellular carcinoma cell migration and metastasis: the role of hypoxia inducible factor 1 pathway. Toxicology letters. 222(2):91-101. 2013.
- Mei L, Chen Y, Wang Z. Synergistic anti-tumour effects of tetrandrine and chloroquine combination therapy in human cancer: a potential antagonistic role for p21. British journal of pharmacology. 172(9):2232-45. 2015.
- Wang H, Liu T, Li L. Tetrandrine is a potent cell autophagy agonist via activated intracellular reactive oxygen species. Cell & bioscience. 5:4. 2015.
- Liu T, Men Q, Wu G. Tetrandrine induces autophagy and differentiation by activating ROS and Notch1 signaling in leukemia cells. Oncotarget. 6(10):7992-8006. 2015.
- Wang Y, Liu Y, Liu X. Citreoviridin Induces Autophagy-Dependent Apoptosis through Lysosomal-Mitochondrial Axis in Human Liver HepG2 Cells. Toxins. 7(8):3030-44. 2015.
Related Products / Services
Please note: All products are "FOR RESEARCH USE ONLY AND ARE NOT INTENDED FOR DIAGNOSTIC OR THERAPEUTIC USE"
